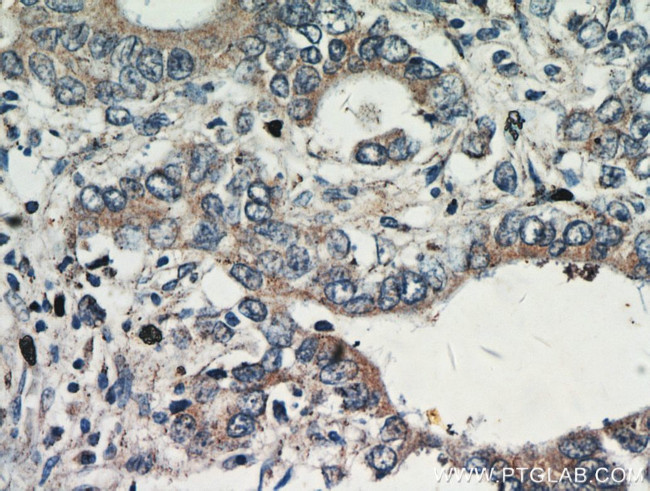
Gastrokine 1 Antibody in Immunohistochemistry (Paraffin) (IHC (P))
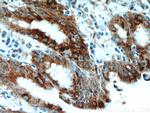
Gastrokine 1 Antibody in Immunohistochemistry (Paraffin) (IHC (P))
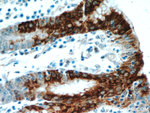
Gastrokine 1 Antibody in Immunohistochemistry (Paraffin) (IHC (P))

Search
Proteintech
Gastrokine 1 Polyclonal Antibody
{{$productOrderCtrl.translations['antibody.pdp.commerceCard.promotion.promotions']}}
{{$productOrderCtrl.translations['antibody.pdp.commerceCard.promotion.viewpromo']}}
{{$productOrderCtrl.translations['antibody.pdp.commerceCard.promotion.promocode']}}: {{promo.promoCode}} {{promo.promoTitle}} {{promo.promoDescription}}. {{$productOrderCtrl.translations['antibody.pdp.commerceCard.promotion.learnmore']}}
产品信息
14494-1-AP
种属反应
宿主/亚型
分类
类型
抗原
偶联物
形式
浓度
纯化类型
保存液
内含物
保存条件
运输条件
产品详细信息
Immunogen sequence: NVNDDNNNA GSGQQSVSVN NEHNVANVDN NNGWDSWNSI WDYGNGFAAT RLFQKKTCIV HKMNKEVMPS IQSLDALVKE KKLQGKGPGG PPPKGLMYSV NPNKVDDLSK FGKNIANMCR GIPTYMAEEM QEASLFFYSG TCYTTSVLWI VDISFCGDTV EN (35-196 aa encoded by BC059778)
靶标信息
Gastrokine 1, also known as GKN1 and CA11, is a 185 amino acid containing secreted protein belonging to the gastrokine family with a BRICHOS domain and an asn-rich region. GKN1 (also known as an antioncogene) is reported to be down-regulated in human gastric cancer tissue as compared to normal gastric mucosa. Differential display of normal and cancerous gastric tissue suggested that this protein is predominantly expressed in stomach and the expression is down-regulated to considerable frequency in cancer tissue or gastric cancer cell lines examined. This extra cellular protein is co-secreted with mucins and is a signaling growth factor with mitogenic activity and may be involved in maintaining the integrity of the gastric mucosal epithelium.
仅用于科研。不用于诊断过程。未经明确授权不得转售。
篇参考文献 (0)
生物信息学
蛋白别名: 18 kDa antrum mucosa protein; AMP-18; BRICHOS domain containing 1; Gastrokine-1; Protein CA11
基因别名: AMP18; BRICD1; CA11; FOV; foveolin; GKN1; UNQ489/PRO1005
UniProt ID: (Human) Q9NS71
Entrez Gene ID: (Human) 56287